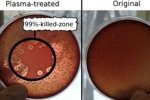
Холодная плазма эффективнее антибиотиков

Тег: Холодная

31 декабря 2015, 11:34
В первые дни нового года на Ставрополье ожидается аномально холодная погода
По данным Ставропольского Гидрометцентра с 1 по 5 января на территории края ожидается аномально холодная погода с температурой воздуха ночью -15°…-20°...

16 мая 2012, 10:26
Холодная война между Пугачевой и Резником продолжается
Теснее малюсенько кого может удивить то событие, что меж 2-мя мэтрами русской эстрады - поэтом-песенником Ильей Резником и певицей Аллой Пугачевой - в...

13 мая 2011, 10:24
Холодная весна не угрожает посевам
В этом году зима долго не хотела уходить со Ставрополья, да и весна выдалась холодной и дождливой. Тем временем на полях уже зазеленели всходы, зацвел...
17 декабря 2010, 06:02
Холодная плазма эффективнее антибиотиков
Струи холодной плазмы могут стать безопасной и эффективной альтернативой антибиотикам при лечении лекарственно-устойчивых инфекций...